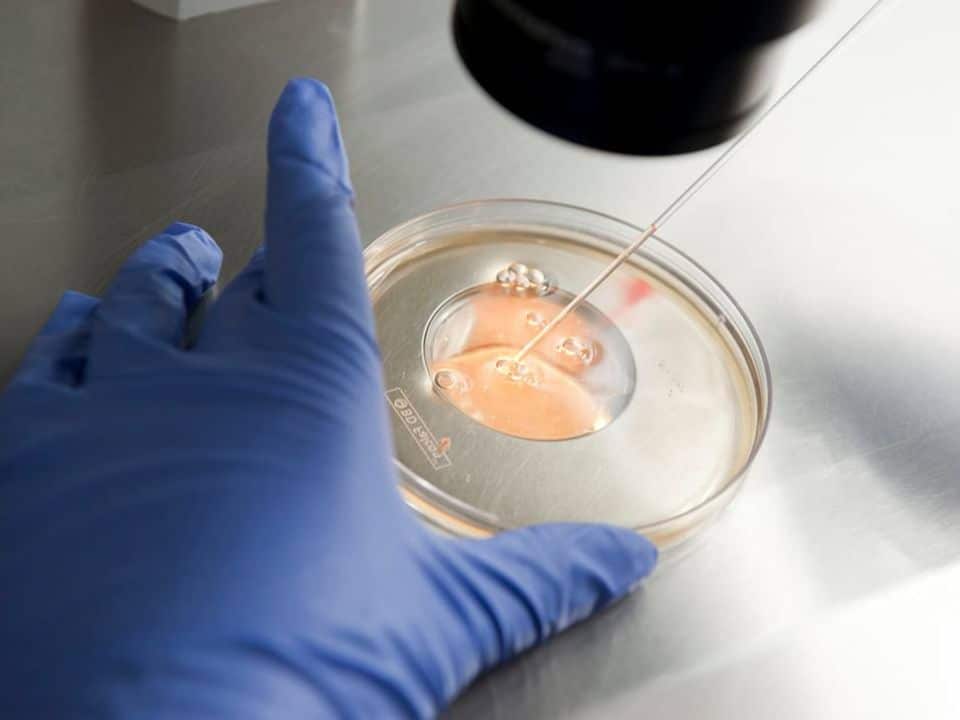
tratamiento-de-fertilizacion-in-vitro-mas-alla-de-la-infertilidad-fiv-procedimiento-fertilizacion-en-laboratorio-fiv-en-ingenes

El tratamiento de Fecundación In Vitro ha evolucionado la forma de concebir bebés en todo el mundo, es considerado un tratamiento de alta complejidad debido a la serie de procedimientos utilizados que aumentan el nivel de probabilidad de éxito, consiguiendo la unión del óvulo y el espermatozoide en un laboratorio, y transfiriendo el embrión formado directamente al útero materno para lograr un embarazo.
Este tratamiento no solo es una alternativa exitosa para casos de infertilidad, ya que también tiene beneficios para que muchas otras mujeres se conviertan en mamás.
¿Quién puede hacerse un tratamiento de Fecundación In Vitro?

Es un tratamiento ideal para parejas que no están en condiciones de tener un bebé, por ejemplo, cuando existen:
- Problemas de ovulación
- Trompas de Falopio bloqueadas
- Endometriosis
- Ovario poliquístico
- Baja calidad y cantidad de esperma
- Edad materna avanzada
Además de ser una excelente alternativa para parejas femeninas, y mujeres solteras, que quieren tener un bebé, e incluso para aquellas que quieren descartar anomalías en su futuro hijo.
¿Cuáles son los beneficios de tener un tratamiento de Fecundación In Vitro?

Como ya mencionamos, el tratamiento de Fecundación In Vitro no es un tratamiento exclusivo para casos de infertilidad, y aunque ha mostrado grandes resultados en este campo, también tiene otros beneficios, como:
- Poner un alto al reloj biológico: la fertilidad en la mujer disminuye a partir de los 35 años, reduciendo la cantidad y calidad de los óvulos, por lo tanto, conseguir un embarazo de forma natural es más difícil, y con la FIV se extraen de la mujer los óvulos de buena calidad, para que la fecundación entre el óvulo y el espermatozoide se produzca en un laboratorio, y así transferir el embrión directamente al útero de la mamá.

- Aumentar la probabilidad de éxito, en comparación con un tratamiento de baja complejidad: la tasa de éxito de la FIV es mucho mayor que la de inseminación artificial, especialmente cuando se realiza bajo un esquema multiciclo, ya que la probabilidad de éxito aumenta en cada ciclo y los procedimientos están más controlados por los médicos especialistas.
- Descartar enfermedades genéticas: cuando existe la posibilidad de que el bebé herede alguna enfermedad, de los padres o de la familia, el Test Genético Preimplantación utilizado en los tratamientos de FIV es muy eficaces, porque se realiza antes de que el embrión sea transferido al útero, para descartar anomalías genéticas y en algunos casos seleccionar el sexo del bebé.

¿Cuáles son los pasos fundamentales de la FIV?
Para realizar un tratamiento de Fecundación In Vitro, además de ser realizado exclusivamente por expertos reproductivos, los pasos que describen el procedimiento son los siguientes:
- Estimulación ovárica: la ovulación de la mujer se estimula con medicación para llevar a cabo el paso 2.
- Extracción de óvulos: los óvulos se extraen con equipo especial y anestesia.
- Fecundación: aquí se produce la fecundación entre el óvulo y el espermatozoide, que se toma de la muestra de semen de la pareja o de un donante.
- Cultivo de embriones: se monitoriza el desarrollo de los embriones para seleccionar los de mejor calidad y transferirlos al útero de la madre.
- Transferencia de embriones: con la ayuda de un catéter, el médico especialista colocará los embriones dentro del útero, y después de aproximadamente 11 días es necesario hacer una prueba de embarazo.
Programas Multiciclos de Fecundación In Vitro en Ingenes

Ingenes es el Instituto de Fertilidad y Genética líder en América Latina, gracias a que tenemos la tasa de éxito más alta, con más de 50.000 bebés nacidos.
Hemos llevado el tratamiento de Fecundación In Vitro al siguiente nivel a través de nuestros Programas Multiciclo, que ofrecen hasta 4 ciclos para tener un bebé y garantizan hasta un 96% de posibilidades de éxito, además de ofrecer servicios de banco de donantes para mujeres solteras y el ROPA (Método de Recepción de Ovocitos de la Pareja) para parejas de mujeres.